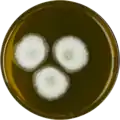
Aspergillus egyptiacus growing on MEAOX plate

| Aspergillus egyptiacus | |
|---|---|
| Scientific classification | |
| Domain: | Eukaryota |
| Kingdom: | Fungi |
| Division: | Ascomycota |
| Class: | Eurotiomycetes |
| Order: | Eurotiales |
| Family: | Aspergillaceae |
| Genus: | Aspergillus |
| Species: | A. egyptiacus |
| Binomial name | |
| Aspergillus egyptiacus Moubasher & Moustafa (1972)[1] | |
Aspergillus egyptiacus is a species of fungus in the genus Aspergillus. It is from the Cavernicolus section.[2] The species was first described in 1972.[1] It was isolated from sandy soil in Egypt.[2]
Growth and morphology
A. egyptiacus has been cultivated on both Czapek yeast extract agar (CYA) plates and Malt Extract Agar Oxoid® (MEAOX) plates. The growth morphology of the colonies can be seen in the pictures below.
 Aspergillus egyptiacus growing on CYA plate
Aspergillus egyptiacus growing on CYA plate Aspergillus egyptiacus growing on MEAOX plate
Aspergillus egyptiacus growing on MEAOX plate
References
- 1 2 Moubasher & Moustafa 1972, Egypt. J. Bot. 15: 153
- 1 2 Chen, A.J.; Frisvad, J.C.; Sun, B.D.; Varga, S.; Kocsubé, S.; Dijksterhuis, J.; Kim, D.H.; Hong, S.-B.; Houbraken, J.; Samson, R.A. (2016). "Aspergillus section Nidulantes (formerly Emericella): Polyphasic taxonomy, chemistry and biology". Studies in Mycology. 84: 1–118. doi:10.1016/j.simyco.2016.10.001. PMC 5198626. PMID 28050053.
Further reading
- Richard J., Cole (2012). Modern Methods in the Analysis and Structural Elucidation of Mycotoxins. Oxford: Elsevier Science. ISBN 978-0-323-14853-5.
- Zhu, editors, Jian Chen, Yang (2014). Solid state fermentation for foods and beverages. Boca Raton: CRC Press, Taylor & Francis Group. ISBN 978-1-439-84496-0.
{{cite book}}:|first1=has generic name (help)CS1 maint: multiple names: authors list (link) - Zohri, AA; Ismail, MA (1994). "Based on biochemical and physiological behavior, where is Aspergillus egyptiacus better placed?". Folia Microbiologica. 39 (5): 415–9. doi:10.1007/BF02814449. PMID 7537240. S2CID 33580083.
- Ismail, M.A.; Zohri, A.A. (March 1994). "Confirmation of the relationships of Aspergillus egyptiacus and Emericella nidulans using progesterone transformation". Letters in Applied Microbiology. 18 (3): 130–131. doi:10.1111/j.1472-765X.1994.tb00825.x. S2CID 84983290.
This article is issued from Wikipedia. The text is licensed under Creative Commons - Attribution - Sharealike. Additional terms may apply for the media files.